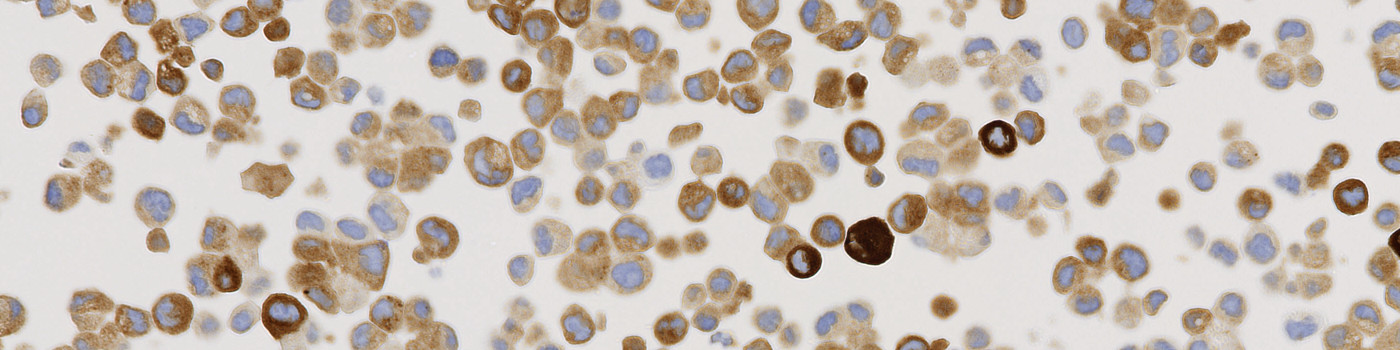
ROS1, Cell Lines, Cancer

Positive cell line core, with strong cytoplasmic granular staining pattern.

#10082
The availability of genetically defined reference materials, offers an industry standard for development and quality control of IHC assays, directly, thereby improving the accuracy and reproducibility.
IHC HDx™ Reference Standards provide laboratories with a consistent source of positive and negative reference material on one slide.
CELL LINE DETAILS
The Staining Pattern of ROS1 Translocation will have a strong cytoplasmic granular staining observed in the positive cell line core. No cytoplasmic, granular staining pattern observed in the negative cell line core. Stained on the Automated Leica BOND stainer (Cell Signalling, D4D6, #3287).
ANALYSIS DETAILS
The ROS1 analysis algorithms for ONCOtopix®, supports the analyser in obtaining accurate, precise quantification of biomarker expression for ROS1 protein. The APP can be configured to provide positive ratio or H-Score. Based on the H-score output, it is possible to Identify the negative, intermediate and positively reacting cores.
The combination of IHC HDx™ Cell lines and the ONCOtopix with the ROS1 APP, provides is the basis of a high quality regent QC system.
Additional information
Defined cores containing positive and negative protein expressing cell lines on the same slide, provides a source of renewable and consistent point of reference when optimizing and monitoring the performance of an IHC assay.
The availability of genetically defined reference materials, offers an industry standard for development and quality control of IHC assays, directly.